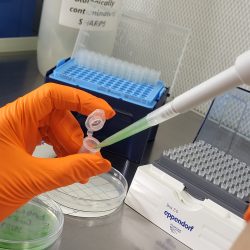
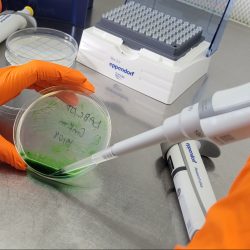

‘Ice bucket challenge’ reveals that bacteria can anticipate the seasons
Bacteria use their internal 24-hour clocks to anticipate the arrival of new seasons, according to research carried out with the assistance of an ‘ice bucket challenge.’
This discovery may have profound implications for understanding the role that circadian rhythms – a molecular version of a clock – play in adapting species to climate change, from migrating animals to flowering plants.
The team behind the findings gave populations of blue-green algae (cyanobacteria) different artificial day lengths at a constant warm temperature. Samples on plates received either short days, equinox days (equal light and dark), or long days, for eight days.
After this treatment, the blue-green algae were plunged into ice for two hours and survival rates monitored.
Samples that had been exposed to a succession of short days (eight hours light and 16 hours dark) in preparation for the icy challenge achieved survival rates of 75%, up to three times higher than colonies that had not been primed in this way.
One short day was not enough to increase the bacteria’s resistance to cold. Only after several short days, and optimally six to eight days, did the bacteria’s life chances significantly improve.
In cyanobacteria which had genes that make up their biological clock removed, survival rates were the same regardless of day lengths. This indicates that photoperiodism (the ability to measure the day-night cycle and change one’s physiology in anticipation of the upcoming season) is critical in preparing bacteria for longer-term environmental changes such as a new season or shifts in climate.
“The findings indicate that bacteria in nature use their internal clocks to measure day length and when the number of short days reaches a certain point, as they do in autumn/fall, they ‘switch’ to a different physiology in anticipation of the wintry challenges that lie ahead,” explained first author of the study, Dr Luísa Jabbur, who was a researcher at Vanderbilt University, Tennessee, in the laboratory of Prof. Carl Johnson when this study took place, and is now a BBSRC Discovery Fellow at the John Innes Centre.
The Johnson lab has a long history of studying the circadian clock of cyanobacteria, both from a mechanistic and an ecological perspective.
Previous studies have shown that bacteria have a version of a biological clock, which could allow them to measure differences in day-night length, offering an evolutionary advantage.
This study, which appears in Science, is the first time that anyone has shown that photoperiodism in bacteria has evolved to anticipate seasonal cues.
Based on these findings a whole new horizon of scientific exploration awaits. A key question is: how does an organism with a lifespan of between six and 24 hours evolve a mechanism that enables it not merely to react to, but to anticipate, future conditions?
“It’s like they are signalling to their daughter cells and their granddaughter cells, passing information that the days are getting short, you need to do something,” said Dr Jabbur.
Dr Jabbur and colleagues at the John Innes Centre will, as part of her BBSRC Discovery Fellowship, use cyanobacteria as a fast-reproducing model species to understand how photoperiodic responses might evolve in other species during climate change, with hopeful applications to major crops.

A key part of this work will be to understand more about the molecular memory systems by which information is passed from generation to generation in species. Research will investigate the possibility that an accumulation of compounds during the night on short days acts as a molecular switch that triggers change to a different physiology or phenotype.
For Dr Jabbur the findings amount to an early-career scientific breakthrough in the face of initial scepticism from her scientific mentor and the corresponding author of the paper, Professor Carl Johnson.
“As well as being a fascinating person and an inspiration, Carl sings in the Nashville Symphony Chorus, and he has an operatic laugh! It echoed round the department when I first outlined my idea for the icy challenge, to see if photoperiod was a cue for cyanobacteria in their natural element,” said Dr Jabbur.
“To be fair he told me to go away and try it, and as I went, he showed me a sign on his door with the Frank Westheimer quote: ‘Progress is made by young scientists who carry out experiments that old scientists say would not work.’
“It did work, first time. Then I repeated the experiments. There is something very precious about looking at a set of plates with bacteria on them and realizing that in that moment you know something that nobody else knows.”
Bacteria can anticipate the seasons: Photoperiodism in cyanobacteria appears in Science.
— ENDS —
Notes for Editors
Press Contacts:
- Hannah Arnold, Hannah.arnold@jic.ac.uk, 01603 450962
- Adrian Galvin, Adrian.Galvin@jic.ac.uk, 01603 450238/07989 339598
Full caption for microscopy images: Microscopy image showing cells of the wild-type cyanobacterium species used in the study. Autofluorescence was pseud-coloured as bright green. Scale bar is 5 micrometers.
About Vanderbilt University, Tennessee
Vanderbilt is a private research university in Nashville, Tennessee. It offers more than 70 undergraduate majors and a full range of graduate and professional degrees across 10 schools and colleges. Vanderbilt is optimized to inspire and nurture cross-disciplinary research that fosters discoveries that have global impact.